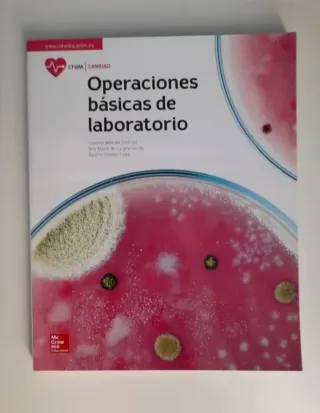
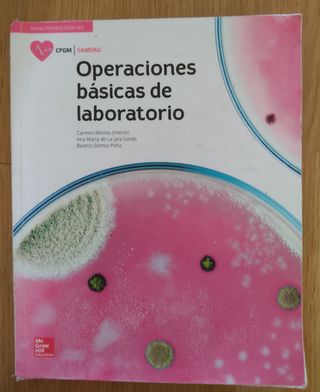

Libros Grado Medio laboratorio de segunda mano
Novedades
Técnico en operaciones de laboratorio (libros)
Tres libros de texto para el grado medio de técnico en operaciones de laboratorio: - Seguridad y organización en el laboratorio. - Pruebas físicoquimicas. - Muestreo y operaciones unitarias de laboratorio. El de pruebas físicoquimicas esta sin marcar, sin usar y sin forrar. Los otros dos están forrados y tienen marcas a lápiz en algunas páginas, como se ve en las imágenes.
Operaciones básicas de laboratorio
Libro de grado medio de farmacia de laboratorio
Operaciones básicas de laboratorio
Libro nuevo, perteneciente al grado medio del área de sanidad de la editorial Mac Graw Hill. Más libros nuevos en mi perfil, pregunta sin compromiso.
OPERACIONES BASICAS LABORATORIO GM 22 CF
Libro de operaciones básicas de laboratorio ,de grado medio de farmacia y parafarmacia, no está pintado ni subrayado
FORMACION Y ORIENTACION LABORAL
Libro llamado Formación y orientación laboral Para el grado superior de Anatomía Patológica o Laboratorio Clínico y Biomédico o cualquier grado medio o superior Nuevo, a estrenar, con página con olor a nuevo Editorial: Arán ISBN: 978-84-92977-56-7 ENVÍOS RÁPIDOS Y CON REGALITO
libros grado medio farmacia
libros grado medio farmacia, tengo todos los de la lista (segunda foto) + OFICINA DE FARMACIA + DISPENSACIÓN DE PRODUCTOS FARMACÉUTICOS +DISPENSACION Y VENTA DE PRODUCTOS + OPERACIONES BÁSICAS DE LABORATORIO
Libros farmacia grado medio
Vendo libros necesarios para próximo curso de grado medio técnico auxiliar de farmacia y parafarmacia -Anatomofisiologia y patologías básicas. -Operaciones básicas de laboratorio. -Itinerario personal para la empleabilidad I 1. -Dispensación de productos para farmacéuticos. -Dispensación y venta de productos. -Oficina de farmacia. -Digitalizacion.
Pack libros 1º de FP Farmacia grado medio
Incluye: 👉🏻Itinerario Personal para la Empleabilidad I – Editorial Paraninfo 👉🏻 Digitalización aplicada a los sectores productivos-McGraw Hill 👉🏻Promoción de la salud – Altamar 👉🏻Dispensación de productos farmacéuticos – Síntesis 👉🏻Primeros auxilios – Altamar 👉🏻Operaciones básicas de laboratorio – McGraw Hill 👉🏻Disposición y venta de productos – Altamar 👉🏻Anatomofisiologia y patología basicas- Altamar 📍 Entrega en mano en Jerez o envío por Wallapop. Se vende pack completo, algunos en condiciones aceptables y otros como nuevos
Operaciones básicas de laboratorio
Este libro cubre los contenidos del ciclo formativo de grado medio y permiten al alumno adquirir las capacidades y habilidades que le preparan para asistir en la elaboración de productos farmacéuticos y parafarmacéuticos, tanto en la oficina de farmacia como en farmacia hospitalaria. En primer lugar se estudian las normas de seguridad y riesgos en la manipulación de sustancias como base para el trabajo en un laboratorio químico. A continuación se presentan los materiales y equipos de laboratorio. Se dan nociones de métodos de medida y unidades y de formulación inorgánica. Se incluyen de forma significativa técnicas de pr

HAGO ENVIOS Operaciones basicas de laboratorio 24
SOY RICARDO C DIEZ AÑOS EN WALLAPOP Y MAS DE 400 VALORACIONES POSITIVAS ME ELIMINARON LA CUENTA EL 19/9/24 Operaciones básicas de laboratorio ISBN 9788448642587 McGraw Hill 28 junio 2024 Farmacia y parafarmacia Grado medio Hago envios

HAGO ENVIO Operaciones básicas de laboratorio
SOY RICARDO C DIEZ AÑOS EN WALLAPOP Y MAS DE 400 VALORACIONES POSITIVAS ME ELIMINARON LA CUENTA EL 19/9/24 Operaciones básicas de laboratorio Altamar 1 julio 2022 ISBN 9788418843334 Farmacia y parafarmacia Grado medio
Libro Operaciónes Básicas De Laboratorio
Libro en buen estado de grado medio libro para la laboratorio para estudios de Farmacia..
Operaciones básicas de laboratorio
Libro nuevo, perteneciente al grado medio de farmacia y parafarmacia de la editorial Altamar. Más libros nuevos en mi perfil, pregunta sin compromiso.
Operaciones básicas de laboratorio
Libro de FP para primer curso de grado medio de farmacia y parafarmacia
Operaciones básicas de laboratorio
libro de texto de operaciones básicas de laboratorio ( ciclo formativo grado medio farmacia y parafarmacia)libro en muy buen estado,forrado, con algunas paginas subrayadas
Operaciones básicas de laboratorio
Grado medio farmacia parafarmacia
Operaciones básicas de laboratorio
Libro Operaciones Básicas de Laboratorio de primer curso de grado medio Farmacia y Parafarmacia En buen estado; páginas subrayadas en lápiz y anotaciones en lápiz. ISBN: 9788448611675
Operaciones básicas de laboratorio
Libro de laboratorio de grado medio farmacia y parafamacia, en perfecto estado. Con la compra del libro daré algunos temas y apuntes de la asignatura.
Libro Laboratorio de química: Servicios auxiliares
Libro segundo curso, grado medio en perfecto estado
Operaciones básicas de laboratorio
Primer curso grado medio farmacia
Libro CFGM: Operacions bàsiques de laboratori.
Libro de Grado medio Farmacia en catlán. En perfecto estado, sin tachones.
Libro farmacia grado medio
Libro farmacia grado medio OPERACIONES BASICAS DE LABORATORIO están muy poco subrayados pero con lápiz fácil de borrar

Libro Grado Medio Farmacia
Libro nuevo, no se ha usado,, Operaciones básicas de laboratorio , editorial Altamar
Operaciones básicas de laboratorio
Libro grado medio farmacia y parafarmacia. Solo trato en mano
Operaciones básicas de laboratorio
Libro de 1 Grado Medio Farmacia y Parafarmacia. Esta en buen estado
Empresa i iniciativa emprenedora. Libro Grado Medi
Libro de grado medio. IES. Miquel Biada. Mataró. Química. Operaciones de Laboratorio.
Libro "Operaciones Básicas de Laboratorio".
Libro en perfecto estado de "Operaciones Básicas de Laboratorio", grado medio 1° de Farmacia y Parafarmacia. No se envía ni rebaja. Más artículos en mi perfil, muchas gracias por visitarlo!!
Prótesis dentales para grado superior
Libros de aprendizaje sobre como fabricar prótesis dentales desde cero, su empleo, manipulación, incluye protocolos, imágenes, etc. Muy didáctico perfecto para alumnos de grado superior que se quiera dedicar a ser protésico y trabajar en laboratorios. Relacionado con la odontología. Contiene algunos apuntes en los tres primeros libros, los demás están sin ninguna escritura. Se conservan en buen estado. Son 11 libros. Incluye Fool (formación y orientación), Inglés relacionada al medio formativo y emprendimiento en empresas.
Almacenamiento y distribución en el laboratorio
Para el grado medio de operaciones de laboratorio
Libros de grado medio de farmacia y parafarmacia
Estan en perfecto estado. El de anatomía esta en color y el de oficina de farmacia y el de operaciones básicas de laboratorio estan los dos en blanco y negro. El precio que pongo es por los tres si se quiere alguno en concreto mas información por privado.

Libros Escolares Grado Basico Medio Superior
Dispongo de muchos libros, pregunta por tu libro para clases o de lectura, ya sea de lectura, ingles, auxiliar enfermeria, laboratorio, mecanica, ciencia ficcion... Tambien dispongo de muchos libros para kindle Pregunta por tu libro aportando ISBN si es posible *NO SON EN FORMATO FISICO TODO DIGITAL*
Lote de libros primero grado medio farmacia
Libros primero de grado medio de farmacia y parafarmacia - Oficina de farmacia - Operaciones básicas de laboratorio - Disposición y venta de productos Como nuevos, no fueron usados.
Libro de operaciones basicas de laboratorio
Libro de operaciones basicas de laboratorio para el grado medio de farmacia y parafarmacia como nuevo
Operaciones básicas de laboratorio
Perfecto estado grado medio farmacia y parafarmacia
Técnicas básicas de microbiología y bioquímica
Grado medio de operaciones de laboratorio
Operaciones básicas de laboratorio
Libro de Operaciones Básicas de Laboratorio del grado medio de farmacia y parafarmacia
OPERACIONES BASICAS LABORATORIO GM 22 CF
Libro grado medio en farmacia y paragarmacia operaciones basicas de laboratorio

Grado medio de Farmacia y Parafarmacia
Como nuevos !!! Libro de Inglés 15 Empresa e iniciativa emprendedora 10 Operaciones básicas de laboratorio 15
Libro Operaciones Básicas de Laboratorio
Grado Medio Farmacia y Parafarmacia
libros primero farmacia
vendo libro de primero de farmacia (grado medio) totalmente nuevos menos el de disposición y ventas de productos y anatomofisiología y patología basicas (esos dos serian 15€) Itinerario personal : 978-84-1134-936-9 laboratorio: 978-84-486-4258-7 ventas: 978-84-486-2288-6 anatomia: 978-84-486-1163-7 p.auxilios:978-84-486-4230-3 digitalización:978-84-1134-930-7 promocion salud: 978-84-486-4725-4 productos para farmacéuticos: 978-84-486-4733-9
Operaciones básicas de laboratorio
Es el libro de farmacia y parafarmacia grado medio primer año
Libros grado medio farmacia + 2 batas laboratorio
En buen estado

Libro operaciones laboratorio
Libro de grado medio de farmacia